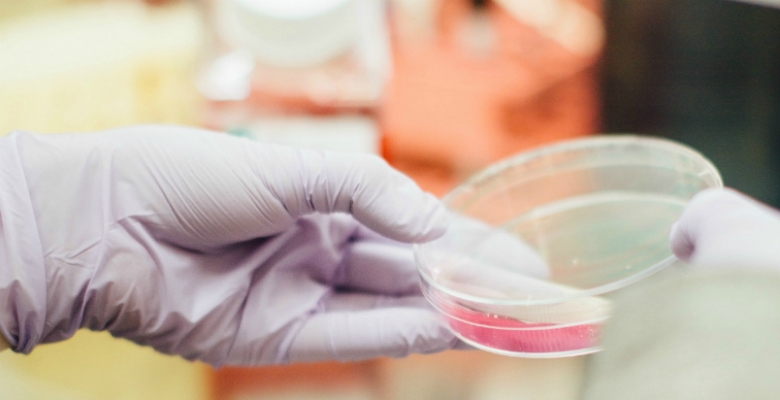

Doentes cardiovasculares não mudam os comportamentos depois de um AVC ou enfarte
Um estudo europeu que envolveu seis países, entre os quais Portugal, concluiu que uma percentagem significativa de doentes não muda os seus comportamentos depois de sofrer um enfarte agudo do miocárdio e/ou um acidente vascular cerebral (AVC).